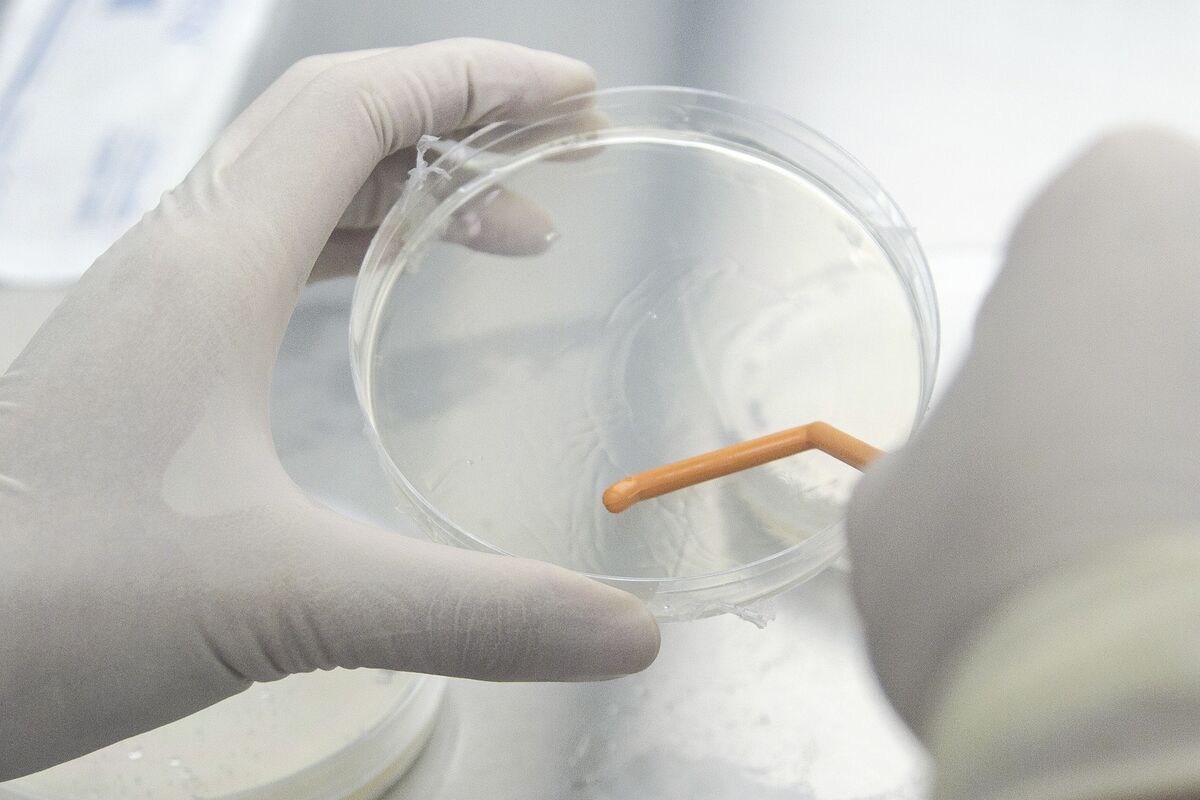

Experts Investigate Mysterious 'Disease X' Outbreak in DR Congo
Africa CDC has deployed experts to the Democratic Republic of Congo to investigate an outbreak of an unknown disease, referred to as "Disease X," which has a high mortality rate among children. The agency is collaborating with local health authorities and international partners to enhance disease monitoring and laboratory capabilities, focusing on genomic surveillance and decentralized infrastructure. This effort aims to improve outbreak response and preparedness, with Africa CDC providing advanced diagnostic tools and expertise to support the investigation and control measures.